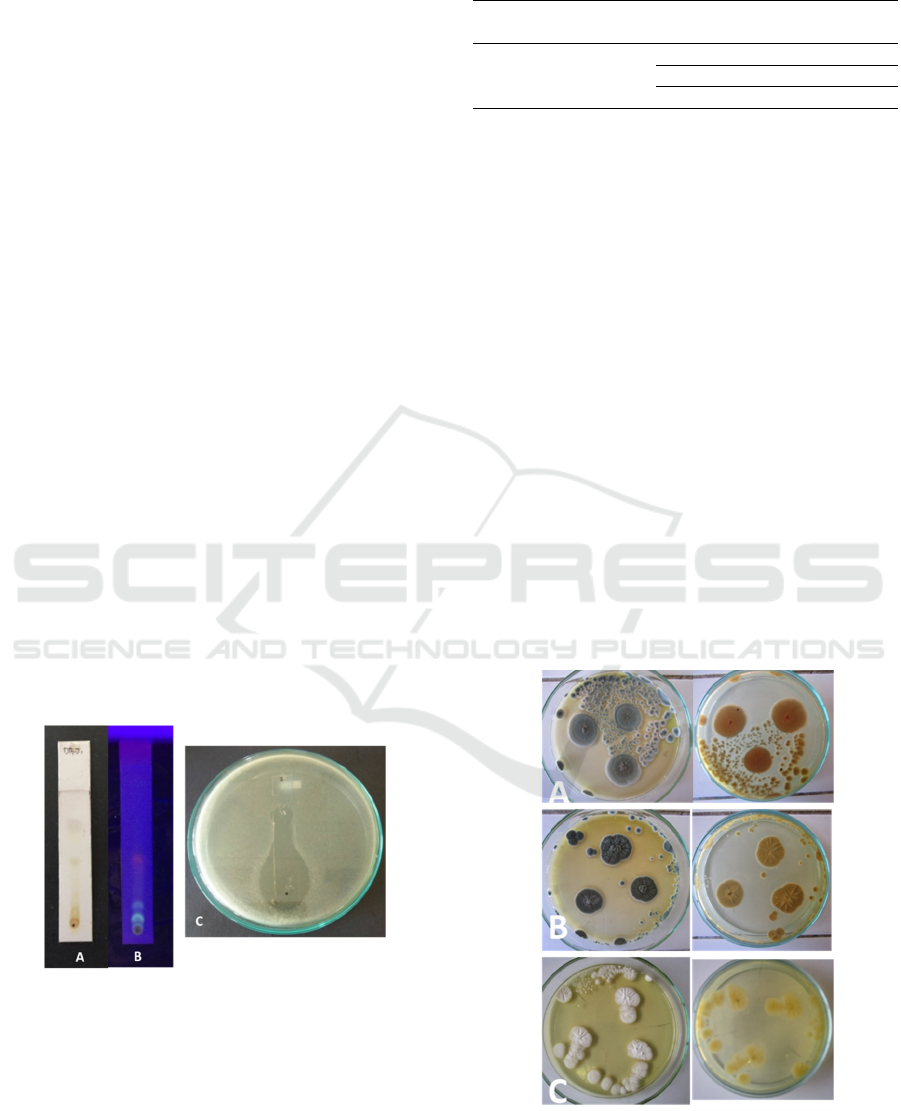

Antimicrobial Activity of Endophytic Fungi from Eleocharis Dulcis
(Burm. f.) Henschell
Elisa Nurnawati, Juliana Hutajulu, Hary Widjajanti and Muharni
Department of Biology, Faculty of Mathematics and Natural Sciences, Sriwijaya University, Palembang, Indonesia
Keywords: Eleocharis Dulcis, Antibacterial Activity, Penicillium Citrinum, Alkaloid, Terpenoid, Phenol.
Abstract: Extracts of endophytic fungi isolated from Eleocharis dulcis were tested for antibacterial ability. Two
isolates showed the strongest activity toward Staphylococcus aureus, Escherichia coli and Salmonella typhi
than another isolates. The results of diffussion methods for antibacterial test of extract of DP1J1 isolate
against Staphylococcus aureus, Escherichia coli and Salmonella typhi were 86.31%, 77.4%, and 83.15%
respectively. MIC extract of DP1J1 isolate against Staphylococcus aureus, Escherichia coli and Salmonella
typhi were 0,03%, 0,02% and 005%, respectively. Based on bioautography test, extract of DP1J1 isolate was
contained alkaloid, phenol and terpenoid. DP1J1 identified as Penicillium citrinum.
1 INTRODUCTION
The search for antibacterial secondary metabolites
from natural materials has been a lot of done.
Relevant to the higher level of resistance of
pathogenic bacteria to commercial antibacterial
compounds. Bioactive plant compounds are
potential source of medicinal ingredients. The use of
plant as raw material for the production of
antibacterial compounds generated new problems.
Utilization of large amounts of plant biomass caused
reduced plant biological resource (Allurappa, et al,
2018).
Water chesnut (Eleocharis dulcis (Burm.f.)
Henschell) are often found in South Sumatra
swamps, especially in Ogan Ilir district. This plant
adapted to acid swamp land conditions. The content
of secondary metabolites is very interesting to know.
The juice of the water chesnut tuber contains
antibiotic compounds which are effective in
inhibiting Staphylococcus aureus, Escherichia coli,
and Aerobacter aerogenes (Asikin dan Thamrin,
2012). Ethanol, ethyl acetate and n-hexane extracts
of water chestnut leaves have been known to contain
triterpenoid compounds, tannins and flavonoids.
These compounds are antibacterial activity (Baehaki
et al., 2018).
Endophytic fungi can be found in plants.
Endophytic fungi was penetrate and live in the plant
tissues which innoxious to the host. The fungi are
able to produce the same bioactive compounds as
plants due to genetic recombination between plants
and fungi followed by coevolution. The ability of
microbes to produce the same bioactive compounds
as plants can be used as a substitute for taking up
very large plant biomass. Endophytic fungi can
produce functional compounds in the form of
anticancer, antiviral, antibacterial, antifungal and
growth hormone for plants (Tan and Zou, 2001;
Noverita et al., 2009)
Plants which adapted to live in unique
environments such as in swampy areas potentially
produce bioactive compounds that are used to
survive. Based on this, endophytic fungi from water
chestnut have not been studied yet, so it is necessary
to explore endophytic fungi from water chestnut that
potentially produce antibacterial compounds against
Staphylococcus aureus, Escherichia coli and
Salmonella typhi.
Nurnawati, E., Hutajulu, J., Widjajanti, H. and Muharni, .
Antimicrobial Activity of Endophytic Fungi from Eleocharis Dulcis (Burm.f.) Henschell).
DOI: 10.5220/0010138000002775
In Proceedings of the 1st International MIPAnet Conference on Science and Mathematics (IMC-SciMath 2019), pages 155-161
ISBN: 978-989-758-556-2
Copyright
c
2022 by SCITEPRESS – Science and Technology Publications, Lda. All rights reserved
155

2 MATERIAL AND METHODS
2.1 Sampling
Water chestnut was obtained from the swamps along
the road between Palembang and Indralaya by
random sampling method. Sampling was carried out
in two locations and the coordinate were S 03 °
08'04.1 " E 104 ° 41 '57.3 "and S 03 ° 08 '39.2" E
104 ° 41 '36.5 ". The samples used in this study
were old roots, stems and leaves with good quality
as a source of fungi isolates
2.2 Isolation of Endophytic Fungi
The roots, stems and leaves are washed in running
water to remove dirt. The part of plants were surface
sterilized gradually by means of samples soaked in
70% alcohol and 0.1% NaOCl alternately then
rinsed with sterile distilled water and dried on sterile
tissue. The part of plants were split and placed on a
PDA medium with the position of the surface of the
sample attached to the agar and then incubated at
room temperature (27°C). Pure fungal isolates were
made into work culture and stock culture on slant
tube medium.
2.3 Cultivation of Endophytic Fungi
Suspended endophytic fungal propagules of ± 10
6
propagules / mL were inoculated in PDB medium
placed in a 1 liter cultivation bottle with two
repetitions. Culture was incubated at room
temperature until the medium undergoes a color
change which indicates that secondary metabolite
compounds have formed. The medium without the
addition of endophytic fungi is used as a control.
After the secondary metabolites are formed, the
fungi biomass is separated from the medium. The
liquid-liquid fractionation medium (partition) with
ethyl acetate solvent and concentrated with a rotary
evaporator.
2.4 Antibacterial Assay (Kirby Bauer
Methods)
The test bacteria that have been equivalent to Mc
Farland 0.5 were spread into the MHA medium.
Disc paper that containing 2% antibacterial extract
and 50 µl of them is placed on the surface of the
MHA media. Tetracyclines with a 0.1%
concentration of 50 µl were used as positive
controls. The culture was incubated at 37 ° C for
1x24 hours (Rosyidah et al., 2010). Determination of
the antibacterial activity of secondary metabolite
extracts was carried out by measuring the diameter
of inhibitory zones formed in secondary metabolite
extracts of endophytic fungi compared diameter of
inhibitory zones on standard antibiotics, tetracycline
(Noverita et al., 2009; Balouiri et al, 2016). The
activity of secondary metabolite extracts tested
against standard antibiotics is determined by the
following equation.
Percentage of ntibacterial activity =
x 100%
A= inhibition zone (mm) of extract
B= inhibition zone (mm) tetracycline (Chan,
2007).
2.5 Minimum Inhibition Concentration
(MIC)
Extracts of secondary metabolites of endophytic
fungi were made in different concentrations of 2%,
1%, 0.5%, 0.25%, 0.125%, 0.06% and control. The
extract was dripped on disc paper and placed on a
bacterial inoculated MHA medium and then
incubated at 37 ° C for 24 hours. The diameter of
inhibition zone formed is observed and measured. If
the lowest concentration was still capable to inhibit
bacterial growth so the extract concentration is
reduced and tested again to the lowest concentration
that was unable to inhibit bacterial growth
(Ruangpan, 2004; Fatisa, 2013).
2.6 Bioautografi Assay
The secondary metabolite extract of endophytic
fungi which showed the highest antibacterial ability
was dissolved with ethyl acetate solvent. Extracts of
secondary metabolites were dripped on TLC plates
and developed with n-hexane: ethyl acetate (8: 2).
TLC plates were sprayed with 10% H2SO4. The
color formed indicates the group of secondary
metabolites.
TLC plates that have been developed are placed
on top of a dense bacterial culture. The spots/stains
on the chromatogram are attached to the medium so
that the compound can diffuse into the agar medium.
The culture was incubated for 24 hours and then a
clear zone was observed which was due to inhibition
of the active compound (Salni et al., 2011; Balouiri
et al, 2016).
2.7 Characterization and Identification
of Endophytic Fungi
Endophytic fungi of water chestnut with highest
antibacterial ability are characterized based on
IMC-SciMath 2019 - The International MIPAnet Conference on Science and Mathematics (IMC-SciMath)
156

macroscopic and microscopic morphology.
Macroscopic morphological characters observed
included colony growth, colony diameter, color of
colony and media and reverse colony. The fungi is
grown in different media (PDA, MEA and Czapex
Dox Agar). Preparation of fungi was observed under
a microscope. Morphological characters of
microscopic fungi were hyphae, hyphae colors,
conidial shapes, conidia colors, and conidial sizes.
Both macroscopic and microscopic characters were
compared with the books (Barnett & Hunter, 2006;
Houbraken et al., 2010).
3 RESULTS AND DISCUSSION
3.1 Isolation of Endophytic Fungi
A total of 9 endophytic fungal isolates were obtained
from the parts of water chestnut (Eleocharis dulcis
(Burm.f) Trinius ex. Henschell). The isolates had 2
isolates from the root, 3 isolates from the stem, and
4 isolates from the leaf. The highest number of
endophytic fungi isolates was found in the leaf tissue
of plants. Endophytic fungi that were isolated from
each of the rat purun tissue have different numbers
and types according to the adaptation of endophytic
fungi to their host plants. According to Noverita et
al., 2009) more than one type of endophytic fungi
can grow from one plant tissue due to the
physiological factors of the host plant, so that
various endophytic fungi are produced.
Table 1: Isolation and Purification of Endophytic Fungi
from Water Chestnut (Eleocharis dulcis (Burm.f) Trinius
ex. Henschell).
Sample Code Total
Root AP
1
J
1
, AP
1
J
2
2
Stem BP
1
J
2
, BP
1
J
3
, BP
1
J
5
3
Leaf DP
1
J
1
, DP
1
J
2
, DP
1
J
3
, DP
1
J
4
4
Total 9
3.2 Antibacterial Activity
Secondary metabolites extract from endophytic
fungi were tested for their antibacterial activity
towards S. aureus, E. coli dan S. typhi. Extracts of
secondary metabolites of endophytic fungi were
tested at 2%. The result of this study was inhibitory
zones formed around the paper disk. The diameter of
inhibition zone formed in testing antibacterial
activity can be seen in Figure 1.
Based on table 2, it is known that all extracts of
endophytic fungal isolates have different
antibacterial activity. This is evidenced by the
formation of inhibition zones around the paper disk.
Based on the criteria for antibacterial activity (Chan
et al., 2007) showed that the result of the percentage
of antibacterial activity of the secondary metabolite
extract of DP1J1 fungi isolates towards three test
bacteria was strongest than the other fungal isolates.
Based on Table 2, the result showed that the
antibacterial activity of DP1J1 isolates against
Escherichia coli, Staphylococcus aureus, and
Salmonella typhi were 77.4%, 86.31%, and 83.15% ,
respectively.
A large percentage of antibacterial activity of the
secondary metabolite extract was obtained from the
area of inhibition zone formed by each isolate. The
diameter of the inhibited zone measured was the
amount of antibacterial compounds that inhibit
bacteria (Balouiri et al., 2016). The higher
antibacterial activity of secondary metabolite extract
of endophytic fungi, the greater of inhibition zone.
Figure 1: Antibacterial Activity Test for Secondary
Metabolite Extracts (a) Escherichia coli (b)
Staphylococcus aureus and (c) Salmonella typhi.
Antimicrobial Activity of Endophytic Fungi from Eleocharis Dulcis (Burm.f.) Henschell)
157

Table 2: Antibacterial Activity of Metabolite Secondary Extract of Endophytic Fungi.
Isolate Origin
of
sample
Concentration
(%)
Antibacterial activity (%) Criteria
E. coli S. aureus S. typhi
AP
1
J
1
Root
2 6,63 4,06 6,31 weak
AP
1
J
2
2 8,84 5,07 12,63 weak
BP
1
J
2
Stem
2 17,69 22,33 23,15 weak
BP
1
J
3
2 11,06 13,20 13,68 weak
BP
1
J
5
2 6,63 19,29 8,42 weak
DP
1
J
1
Leaf
2 77,40 86,31 83,15 strong
DP
1
J
2
2 13,27 10,15 18,94 weak
DP
1
J
3
2 15,48 11,16 10,52 weak
DP
1
J
4
2 11,06 18,27 13,68 weak
Tetracycline 0,1
Criteria of anticaterial activity : <50% (weak), 50-74% (medium), ≥75% (strong) (Chan et al., 2007).
3.3 Minimum Inhibitory Concentration
(MIC)
The aimed of determination of Minimum Inhibitory
Concentration (MIC) was to know the lowest
secondary metabolite extract concentration value
capable to inhibit the growth of test bacteria
(Andrews, 2001). The extract concentration were
2%, 1%, 0.5%, 0.25%, 0.125%, and 0.06%. The
MIC value of secondary metabolite extract of DP1J1
isolates was determined because of strongest
antibacterial activity against the three test bacteria.
Table 3: Minimum Inhibitory Concentration (MIC) of
secondary metabolite extract towards E. coli, S aureus and
S. typhi.
Based on Table 3, the results showed that
inhibition of E. coli growth to ensue at 0.06% - 2%
of secondary metabolite extract DP1J1 isolates. In
0.06% of secondary metabolite extracts were still
capable to inhibit test bacteria, so the concentration
was reduced from 0.06% to 0.01%. Andrews (2001)
certify that antibacterial compounds at the smallest
levels with clear inhibition zone without the growth
of test bacteria are determined as MIC. The MIC
value obtained from the secondary metabolite
extract of DP1J1 isolates against E. coli was 0.03%.
The secondary metabolite extract of DP1J1 isolates
was still able to inhibit the S. aureus at a
concentration of 0.06%, so the concentration was
reduced from 0.06% to 0.01%. The MIC value of
DP1J1 secondary metabolite extract after
concentration reduction was obtained by 0.02%. The
secondary metabolite extract of DP1J1 isolates at a
concentration decrease of 0.06% was still able to
inhibit the S. typhi. Therefore the concentration of
DP1J1 isolates was reduced in concentration of
DP1J1 isolates from 0.06% to 0.01%. The results of
the MIC value of the secondary metabolite extract of
DP1J1 isolates were 0.05%.
The secondary metabolite extract of DP1J1
isolates had different MIC values for different types
of bacteria. The MIC value of metabolite extracts
secondary to the Staphylococcus aureus was lowest
than other bacteria because of differences in
sensitivity of gram-positive bacteria to gram-
negative bacteria against antibacterial. According to
Ullah & Ali (2017) differences in sensitivity of
gram-positive and gram-negative bacteria due to
differences in the structure of the cell wall where
gram-negative bacteria have a relatively more
complex cell wall structure, while gram-positive
bacteria that have a simpler cell wall structure so
that the test compounds which is active as an
antibacterial more easily enter the cell..
S. aureus is a Gram-positive bacterium with
thick peptidoglycan on cell wall. Based on the
results of the study, the MIC value of S. aureus was
lowest, so it can be assumed that the secondary
Isolate (%) Diameter of inhibition zone (mm)
E. coli S. aureus S. typhi
DP
1
J
1
2 10 15 18
1 8,5 10 15
0,5 6,5 10 10
0,25 5 9 7
0,125 5 7 6
0,06 4 5 4
Control 0 0 0
0,06 3,5 2 3
0,05
3 2
2
0,04 2,5 1,5 0
0,03 2
1 0
0,02
0
1
0
0,01 0 0 0
Control 0 0 0
IMC-SciMath 2019 - The International MIPAnet Conference on Science and Mathematics (IMC-SciMath)
158
metabolite content of DP1J1 fungi isolates was
easier to inhibit Gram-positive bacteria. The greatest
MIC value of secondary metabolite extract was S.
typhi compared to the other bacteria. It has been
known that S. typhi was pathogenic, so on the cells
contain a certain protein that interacts with
antibiotics (Lee et al., 2019)
3.4 Bioautography Test of Secondary
Metabolite Extracts
The result of bioautographic test of secondary
metabolite extracts using thin layer chromatography
(TLC) method showed that the secondary metabolite
extracts of endophytic fungi isolate DP1J1 contained
antibacterial compounds. Wardhani and Sulistyani
(2012) have determined the class of active
compounds which are potentially antibacterial using
thin layer chromatography (TLC). Based on the
research results obtained by the price of Rf
(retondation factor) antibacterial active compounds
in extracts of secondary metabolites of endophytic
fungi are presented in Table 4.
Determination of the class of active compound of
secondary metabolite extract was carried out on a
chromatogram sprayed with 10% H
2
SO
4
. If the
cromatogram appeared purple stains which were
thought to be terpenoid group antibacterial
compounds. The active compound on the
chromatogram is attached to the agar medium, after
incubating it shows the results of the formation of a
clear zone around the chromatogram stain as in
Figure 2.
Figure 2: Bioautography test of secondary metabolite
extract. (a) Under visible light, (b) Under UV light, (c)
Bioautography test on agar medium
Table 4: Bioautographic Test Results and Rf Values of
Endophytic Fungal Secondary Metabolite Extracts.
Isolate Total
com
p
ounds
Rf color class of
com
p
ounds
DP
1
J
1
3
0,14
b
rown Alkaloi
d
0,52 yellow Fenol
0,62 violet Ter
p
enoid
Based on the results of the study, it was found
that DP1J1 isolate had 3 active compounds according
to the number of stains formed on the chromatogram.
The clear zone formed in the bioautographic test was
found in the second stain which was suspected to be
phenol group with an Rf value of 0.52.
3.5 Characterization and Identification
of Endophytic Fungi
DP1J1 isolate was identified based on macroscopic
and microscopic morphological characters. DP1J1
isolate was grown on three fungi growth media,
namely Czapek Agar, MEA, and PDA. The colony
color on the PDA was different from the other
media. Colony color on PDA showed white colony
and slow growth with a colony diameter of ± 1 cm.
On the other hand, colony color on MEA showed
deep green color with a white edge, the opposite
color of the brownish yellow colony and a colony
diameter of ± 1.8 cm. On CDA medium, the color of
the colony formed was bluish green with a white
edge and a diameter of ± 1.5 cm (Figure 3).
Figure 3: Macroscopic morphology of DP1J1 isolate. (a)
PDA (top and reverse), (b) MEA (top and reverse), (c)
Czapek (top and reverse).
Antimicrobial Activity of Endophytic Fungi from Eleocharis Dulcis (Burm.f.) Henschell)
159

Microscopic morphology characters were
branched conidiophore, biverticillate, round conidia,
light brown conidia, and phialid flask-shaped
(Figure 4). Based on the microscopic character,
suspected DP1J1 isolate as Penicillium citrinum
(Barnett & Hunter, 2006; Houbraken et al., 2010).
Figure 4: Microscopic morphology of DP1J1 isolate.
The content of compound in the secondary
metabolite Penicilium citrinum were alkaloid,
phenol, and terpenoid compounds. Penicilium
citrinum have the ability to produce antibacterial
compounds which consist of three active
compounds. This study was compatible with the
research of Zhan et al (2014) which declare that the
result of chromatography test the Eleocharis dulcis
ethyl acetate fraction has been obtained bioactive
compounds in the form of flavonoids. Thus,
endophytic fungi isolates DP1J1, identified as
Penicilium citrinum, which were isolated from water
chestnut (Eleocharis dulcis) had the potential to
produce antibacterial compounds in all three test
bacteria. That is important to know is the group of
compounds that are active as antibacterial. Therefore
further examination of each class of these
compounds should be done.
4 CONCLUSION
Based on the results of the research, from 9
endophytic fungal isolates of water chestnut
(Eleocharis dulcis (Burm.f) Trinius ex. Henschell),
it was found that DP1J1 isolates showed strong
antibacterial activity against E. coli ATCC8739, S.
aureus ATCC6538, and S. typhi IPBCC B.11.669.
MIC value of DP
1
J
1
isolate were 30 µg/ml, 20 µg/ml
and 50 µg/ml towards E. coli ATCC8739, S. aureus
ATCC6538 and S. typhi IPBCC B.11.669,
respectively. DP
1
J
1
isolate has been identified as
Penicillium citrinum.
ACKNOWLEDGEMENTS
The authors thanks to Dr. Salni, MSi for the
discussion during the research and Universitas
Sriwijaya for granted Hibah Penelitian Sateks
funded via Anggaran DIPA Universitas Sriwijaya
No : SP DIPA-042.01.2.400953/2019, 5 Desember
2018.
REFERENCES
Allurappa, R. Chowdappa, S., Narayanaswamy, R.,
Sinniah, U.R., Mohanty, S.K. & Swamy, M.K. 2018.
Endophytic Fungi and Bioactive Metabolites
Production: An Update. In: Microbial Biotechnology.
Volume 2. Application in Food and Pharmacology.
Patra, J.K., Dis, G. & Han, S.S (Eds.). Springer.
Andrews, J.M. 2001. Determination of Minimum
Inhibitory Concentration. Journal of Antimicrobial
Chemotheraphy. 48. Suppl. S1. 5 - 16.
Asikin, S., & Thamrin, M. 2012. Manfaat Purun Tikus
(Eleocharis dulcis) Pada Ekosistem Sawah Rawa.
J.Litbang Pertanian. 31 (1): 35-42.
Baehaki, A., Herpandi & Putra, A.A. 2018. Antibacterial
Activity of Extract from Swamp Plant, Eleocharis
dulcis. Oriental Journal of Chemistry. 34(1):573-575.
Balouiri, M., Sadiki, M. & Ibnsouda, S.K. 2016. Methods
for in-vitro evaluating antimicrobial activity : A
review. Journal of Pharmaceutical Analysis. 6:71-79.
Barnett, H.L. & Hunter, B.B. 2006. Illustrated Genera of
Imperfect Fungi 4
th
Ed. Amer Phytopathological
Society.
Chan E.C.W., Lim, Y.Y., & Mohammed, O. 2007.
Antioxidant and Antibacterial Activity of Leaves of
Etlingera Spescies (Zingiberaceae) in Peninsular
Malaysia. Food Chemistry. 104: 1586-1593.
Fatisa, Y. 2013. Daya Antibakteri Estrak Kulit & Biji
Buah Pulasan (Nephelium mutabile) Terhadap
Staphylococcus aureus & Escherichia coli Secara In
Vitro. J. Peternakan. 10 (1): 31-38.
Houbraken, J.A.M.P, Frisvad, J.C, & Samson, R.A. 2010.
Taxonomy of Penicillium citrinum and related species.
Fungal Diversity. 44: 117-133.
Lee HS, Lee S, Kim J-S, Lee H-R, Shin H-C, Lee M-S, Jin
KS, Kim C-H, Ku B, Ryu C-M & Kim SJ .2019.
Structural and Physiological Exploration of
Salmonella typhi YfdX Uncovers Its Dual Function in
Bacterial Antibiotic Stress and Virulence. Frontiers in
Microbiology. 9:3329. doi: 10.3389/fmicb.2018.03329
Noverita, Fitria, D., & Sinaga, E. 2009. Isolasi & Uji
Aktivitas Antibakteri Jamur Endofit Dari Daun &
Rimpang Zingiber ottensii Val. J. Farmasi Indonesia.
4 (4): 171-176.
Rosyidah, K., Nurmuhaimina, S.A., Komari, N., & Astuti,
M.D. 2010. Aktivitas Antibakteri Fraksi Saponin Dari
Kulit Batang Tumbuhan Kasturi (Mangifera casturi).
J. Alchemy. 1 (2): 53-103.
IMC-SciMath 2019 - The International MIPAnet Conference on Science and Mathematics (IMC-SciMath)
160

Ruangpan, L. 2004. Minimal inhibitory concentration
(MIC) test and determination of antimicrobial
resistant bacteria. In Laboratory manual of
standardized methods for antimicrobial sensitivity
tests for bacteria isolated from aquatic animals and
environment (pp.31-55). Tigbauan, Iloilo, Philippines:
Aquaculture Department, Southeast Asian Fisheries
Development Center
Salni, Marisa, H., & Mukti, R. W. 2011. Isolasi Senyawa
Antibakteri Dari Daun Jengkol (Pithecolobium
lobatum Benth) dan Penentuan Nilai KHM-nya. J.
Penelitian Sains. 14 (1): 38-41.
Tan, R.X., & Zou, W.X. 2001, Endophytes: A Rich
Source of Functional Metabolites. J. Natural Product
Report. 18: 448-459.
Ullah, H & Ali, S. 2017. Classification of Anti‐Bacterial
Agents and Their Functions. In : Antibacterial Agents.
Edited by:Kumavath, R. 1-18
Wardhani dan Sulistyani. 2012. Uji Aktivitas Antibakteri
Ekstrak Etil Asetat Daun Binahong (Anredera
scandens (L.) Moq.) Terhadap Shigella flexneri
Beserta Profil Kromatografi Lapis Tipis. J. Ilmiah
Kefarmasian. 2 (1): 1-16.
Zhan, G., Pan, L., Mao, S., and Zhang, W. 2014. Study on
Antibacterial Properties and Major Bioactive
Constituents of Chinese Water Chestnut (Eleocharis
dulcis) Peels Extract/Fraction. European Food
Research and Technology. 238 (5): 789-796.
Antimicrobial Activity of Endophytic Fungi from Eleocharis Dulcis (Burm.f.) Henschell)
161
